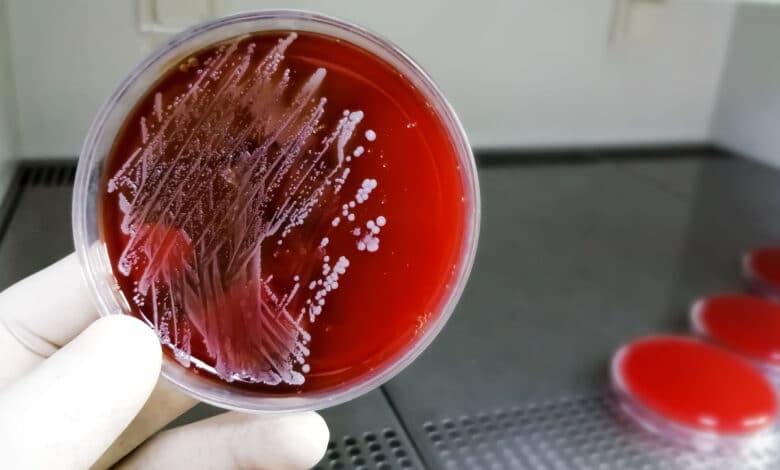
stafilococco

Stafilococco: che cos’è e come curarsi?
Tutte le infezioni causate da questo batterio e i rimedi utili per debellarlo, ricorrendo agli antibiotici naturali
Lo Stafilococco è un batterio Gram-positivo già presente nel corpo.
Vi sono più di 30 diversi tipi di stafilococco che possono infettare l’uomo, ma la maggior parte delle infezioni sono però provocate dallo stafilococco aureo, la specie patogena per eccellenza appartenente al genere stafilococco.
Si tratta infatti di uno dei virus patogeni più comuni, sia in ambito comunitario che in ambito ospedaliero.

Sommario
- Stafilococco: cos’è
- Dove è presente lo Stafilococco Aureo?
- Stafilococco: contagio
- Stafilococco, cause
- Stafilococco sintomi
- Stafilococco al naso, sintomi
- Come si diagnostica lo Stafilococco aureo?
- Come si guarisce da un’infezione da stafilococco?
- Quanto dura un’infezione da Stafilococco?
- Come combattere lo stafilococco
- Stafilococco rimedi naturali
- Altro
Stafilococco: cos’è
Lo stafilococco è un batterio Gram-positivo presente nel nostro corpo, la cui forma sembra ricordare quella di un grappolo d’uva. Il nome completo è in realtà Stafilococco aureo. Si diffonde mediante la saliva, per via diretta, ma anche ingerendo il cibo già intossicato.
Questo batterio normalmente non procura problemi. L’infezione scatta nel momento in cui riesce a penetrare nell’interno del corpo, mediante tagli o lesioni.
Etimologia
Il nome Staphylococcus deriva dal greco staphyle, che significa “grappolo d’uva” e kokkos, che vuol dire “bacca”. Questo è un chiaro riferimento alla forma rotondeggiante dello stafilococco che, per l’appunto, assomiglia a un grappolo d’uva o a delle piccole bacche rotonde.
Aureus deriva invece dal latino e significa “dorato” perché i batteri sono di colore giallognolo.
Dove è presente lo Stafilococco Aureo?
Questo batterio è presente in diverse zone del nostro corpo e procurerà sintomi specifici in base alla zona interessata.
Vive tranquillo sulla pelle del 20-30% delle persone sane e, oltre che sulla cute, si trova solitamente anche nel tratto urinario, nelle mucose e nel tratto respiratorio.
Stafilococco: contagio
Questo batterio è presente in diverse zone del nostro corpo e procurerà sintomi specifici in base alla zona interessata. Tali infezioni sono altamente contagiose, per cui se si viene a contatto con una persona infetta, è molto alta la probabilità di ammalarsi.
L’infezione da Stafilococco può essere contratta mediante contatto fisico. Il rischio di svilupparla è aggravato dalla presenza di tagli o ferite e dal contatto con persone o superfici contaminate dal batterio.
Sono soggetti particolarmente a rischio:
- i bambini piccoli con scarsa igiene personale
- persone con patologie croniche come il diabete, il cancro, le malattie vascolari e quelle polmonari
- le persone con lesioni cutanee
- i soggetti con sistema immunitario indebolito
- chi è dotato di catetere per via endovenosa
- chi ha subìto incisioni chirurgiche
- le donne mestruate
- i tossicodipendenti
- donne in stato di allattamento
Il contagio per via indiretta, che avviene invece attraverso l’assunzione di alimenti contaminati, viene determinato dalla moltiplicazione dei batteri che producono tossine. Generalmente sono colpiti il latte, gli insaccati e i formaggi. Grande attenzione va riservata anche al cibo preparato in casa.
Stafilococco, cause
Lo staphylococcus aureus è causato da contagio sia diretto che indiretto da parte di un soggetto sano.
Altra causa piuttosto comune del contagio dello Stafilococco aureo è principalmente l’assunzione di alimenti contaminati, quali:
- le carni crude
- il latte
- i formaggi
Infine, sono anche frequenti le infezioni da stafilococco dovute a manovre chirurgiche, come l’inserzione di cateteri vescicali, perché lo stafilococco aureo può facilmente contaminare la strumentazione chirurgica come guanti, aghi, cateteri etc…

Stafilococco sintomi
Come già anticipato, i sintomi sono diversi in funzione della localizzazione dell’infezione. Vediamo meglio le forme più diffuse:
- Mucosa orale: la presenza di questi batteri a livello di naso e gola può procurare tonsilliti e mal di gola.
- Urine: la cistite è una delle infezioni maggiormente diffuse.
- Apparato gastrointestinale: generalmente si tratta di infezioni successive al contagio mediante alimenti. I sintomi saranno diarrea, nausea e vomito.
- Pelle: lo stafilococco può causare la follicolite e la formazione di pustole e vesciche doloranti. L’area interessata può essere arrossata, gonfia e indolenzita.
- Febbre e brividi: classici sintomi che compaiono se lo stafilococco aureo ha infettato il sangue
- Pressione sanguigna bassa: ulteriore indizio di infezione sanguigna dello staphylococcus aureus
Nei casi più gravi, questo batterio potrebbe raggiungere le articolazioni, causando ascessi, o gli stessi polmoni, dove è alta la possibilità di sviluppare una polmonite.
SPECIALE: Mononucleosi, contagio, sintomi e cure naturali
Stafilococco al naso, sintomi
I potenziali sintomi di un’infezione da stafilococco nel naso includono:
- rossore
- gonfiore
- incrostazione
- lieve sanguinamento
- lesioni che trasudano pus o altro liquido
- dolore
- febbre
Come si diagnostica lo Stafilococco aureo?
Nei casi meno gravi, non ha bisogno di essere diagnosticato tramite test o esami. Basta una semplice visita medica.
Al contrario, le infezioni da staphylococcus aureus più gravi richiedono coltura di campioni di fluidi corporei infetti o sangue.
Come si guarisce da un’infezione da stafilococco?
In molti casi, le infezioni da stafilococco aureo guariscono da sé, senza che che sia necessario ricorrere ad un trattamento medico. In altri casi, tuttavia, le infezioni della pelle devono essere drenate e pertanto può essere necessario assumere degli antibiotici.
Quanto dura un’infezione da Stafilococco?
Di media, i pazienti con batteriemia da stafilococco coagulasi-negativo semplice o senza complicazioni, hanno ricevuto rispettivamente fino a 3 giorni o 5 giorni di terapia antibiotica. Al contrario, i pazienti con batteriemia da Staphylococcus aureus con complicazioni hanno ricevuto 14 giorni di terapia.
Come combattere lo stafilococco
Generalmente lo stafilococco viene curato mediante trattamento antibiotico (per via orale, con un unguento o per via endovenosa). Ovviamente è sempre necessaria una diagnosi corretta da parte del medico, il quale prescriverà la terapia più adeguata. In alcuni casi sarà necessario effettuare ulteriori indagini diagnostiche per avere la certezza dell’infezione. Ad esempio nel caso specifico di mal di gola persistente, potrà essere prescritto un tampone faringeo.
Lo sapevi? Troppi antibiotici negli allevamenti: aumenta la resistenza dei batteri
Stafilococco rimedi naturali
Chi vuole evitare l’assunzione di antibiotici, tanto dannosi per la nostra salute, può sempre ricorrere a specifici rimedi naturali. Sono tante infatti le piante che agiscono mediante proprietà antibatteriche davvero eccezionali. Ecco allora alcuni dei migliori antibiotici naturali:
- Tea tree oil: noto per le sue capacità di debellare infezioni e funghi, può essere utilizzato come unguento con cui disinfettare infezioni cutanee.
- Aceto di mele: oltre a combattere i batteri, rinforza anche le difese immunitarie. Si può applicare sulle ferite o si può bere versandone 1 cucchiaio in un bicchiere di acqua tiepida.
- Aglio: potete utilizzarlo come un vero e proprio antibatterico naturale. Spalmatelo sulla zona interessata o mangiatelo crudo. Dovrete sopportare l’alito pesante, ma ne varrà la pena.
- Echinacea: fatene un infuso lasciando qualche foglia nell’acqua per qualche minuto; oppure acquistate la pomata di echinacea, da spalmare direttamente sulle lesioni.
- Curcuma: potete utilizzare la polvere per preparare un te. Versatene qualche cucchiaino in una tazza di acqua calda. In alternativa utilizzatelo sulle ferite, sempre sotto forma di polvere.

Altro
Scopri tutti i rimedi naturali per le principali problematiche di salute:
- Candida: rimedi naturali e consigli
- Ascesso dentale, rimedi naturali
- Colon irritabile: sintomi, rimedi e alimentazione corretta
- Blefarite e rimedi naturali: impacchi, cibo e igiene
- Otite: prevenzione e rimedi naturali per questa infezione
- Raffreddore: rimedi e cure naturali
- Tracheite: sintomi, rimedi e cure naturali
- Congiuntivite: come curarla con rimedi naturali
- Tosse grassa: rimedi e cura naturali da provare
Ultimo aggiornamento il 30 Aprile 2025 da Rossella Vignoli
Iscrivetevi alla newsletter di Tuttogreen.it per rimanere aggiornati sulle ultime novità.



